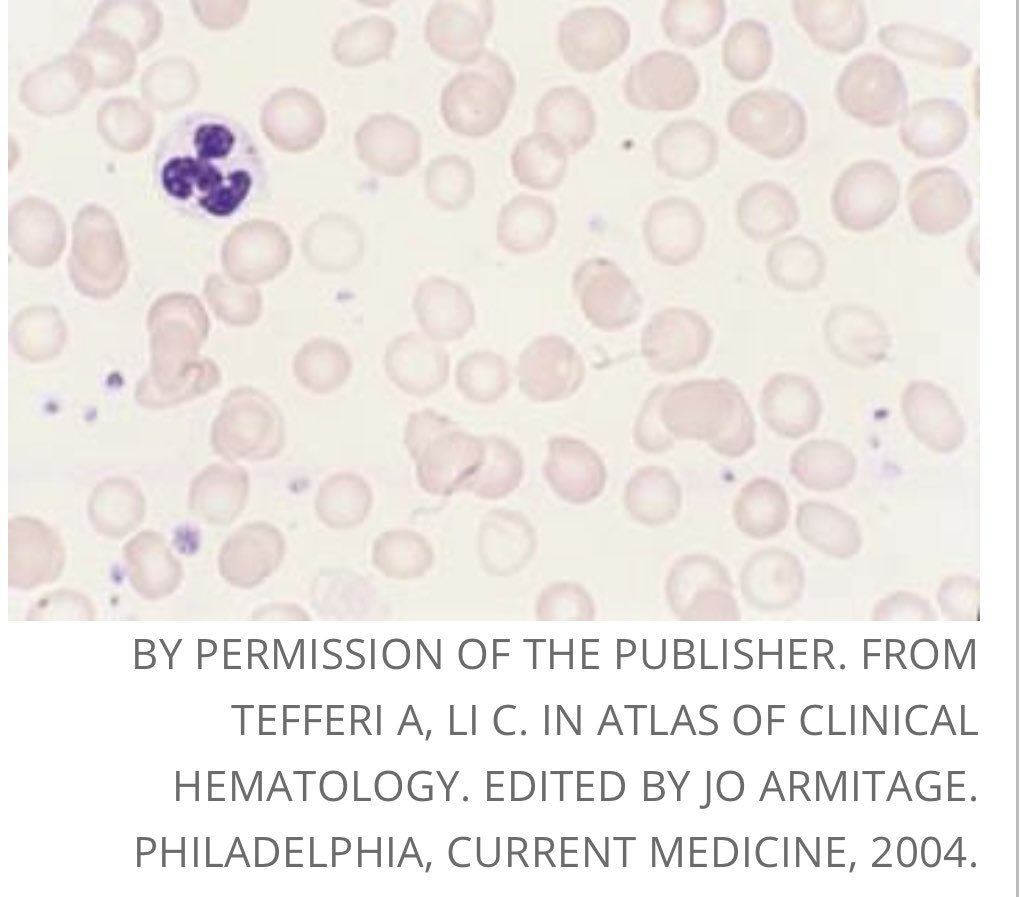

🔴هل سبق وشفت طفل يأكل أشياء غريبة بشراهة مثل: تراب،فحم،ثلج،ورق أو يقشر طلاء الجدار ويأكله؟
هذا غالباً بسب نقص الحديد وفقر الدم ويطلق عليه (بايكا)
الأطفال عمر سنة أو أكثر الذين يشربون الحليب البقري بكثرة أكثر عرضه لفقر الدم بسبب نقص الحديد. تابع السرد🧵لتكون واعي وتحمي أطفالك.
هذا غالباً بسب نقص الحديد وفقر الدم ويطلق عليه (بايكا)
الأطفال عمر سنة أو أكثر الذين يشربون الحليب البقري بكثرة أكثر عرضه لفقر الدم بسبب نقص الحديد. تابع السرد🧵لتكون واعي وتحمي أطفالك.
فقر الدم (الأنيميا) يعني نقص في مستوى كريات الدم الحمراء عن المعدل الطبيعي حسب المرحلة العمرية للطفل.
كريات الدم الحمراء تحمل بروتين الهيموجلوبين وهذا البروتين مهم في حمل الأكسجين من الرئة وتوصيله لكافة أعضاء الجسم لتقوم بالوظائف الحيوية.
كريات الدم الحمراء تحمل بروتين الهيموجلوبين وهذا البروتين مهم في حمل الأكسجين من الرئة وتوصيله لكافة أعضاء الجسم لتقوم بالوظائف الحيوية.
🔴 معلومة جداً مهمة أن الهيموجلوبين يتكون من بروتين وحديد (iron). وإذا نقص أي من هذه المكونات يؤدي إلى نقص الهيموجلوبين.
هناك عدة مسببات أخرى لنقص الهيموجلوبين (كتكسر كريات الدم الحمراء، نزيف حاد، وجود خلايا سرطانية في نخاع العظم وغيرها يبغالها سرد أخر).
هناك عدة مسببات أخرى لنقص الهيموجلوبين (كتكسر كريات الدم الحمراء، نزيف حاد، وجود خلايا سرطانية في نخاع العظم وغيرها يبغالها سرد أخر).
🔴 ماهي أعراض فقر الدم؟
كثير من الأطفال لا يوجد لديهم أي أعراض ويُكتشف فقر الدم عن طريق التحاليل.
ولكن الأعراض بشكل عام تشمل التعب، شحوب الوجه، الإعياء، الإغماء، صداع (أو يكون الطفل متضايق وليس مرتاح)، ضيق في النفس وزيادة في ضربات القلب أو أكل أشياء غريبة غير قابلة للأكل.
كثير من الأطفال لا يوجد لديهم أي أعراض ويُكتشف فقر الدم عن طريق التحاليل.
ولكن الأعراض بشكل عام تشمل التعب، شحوب الوجه، الإعياء، الإغماء، صداع (أو يكون الطفل متضايق وليس مرتاح)، ضيق في النفس وزيادة في ضربات القلب أو أكل أشياء غريبة غير قابلة للأكل.
١- أثبتت دراسات علمية أن الكالسيوم (الموجود في الحليب) يمنع أمتصاص الحديد من الأمعاء.
٢- الطفل الذي يشرب حليب بقري أكثر من ٧٠٠ مل (٣ كاسات)في اليوم يزيد من إحتمالية الإصابة بفقر الدم.
٣- ضعف الأكل وعدم تنوع مصادر الطعام الغنية بالحديد لأن الطفل معتمد على شرب الحليب فقط.
٢- الطفل الذي يشرب حليب بقري أكثر من ٧٠٠ مل (٣ كاسات)في اليوم يزيد من إحتمالية الإصابة بفقر الدم.
٣- ضعف الأكل وعدم تنوع مصادر الطعام الغنية بالحديد لأن الطفل معتمد على شرب الحليب فقط.
🔴 كيف يتم التأكد أن الطفل لديه فقر الدم بسبب نقص الحديد؟
الطريقة الوحيدة هي تحاليل الدم التالية:
CBC يقيس مستوى فقر الدم
Ferritin يقيس مخزون الحديد في الجسم
Iron
Total iron binding capacity
الطريقة الوحيدة هي تحاليل الدم التالية:
CBC يقيس مستوى فقر الدم
Ferritin يقيس مخزون الحديد في الجسم
Iron
Total iron binding capacity
🔴 كيف نعالج #فقر_الدم بسبب #نقص_الحديد؟
▫️متابعة مع طبيب أطفال
▫️تقليل شرب الحليب البقري الى ١-٢ كاسة في اليوم.
▫️تنوع مصادر الأكل الغني بالحديد.
▫️إعطاء الطفل دواء حديد Ferrous Sulfate
▫️إعادة التحاليل بعد شهر للتأكد من الإستجابة للعلاج.
▫️متابعة مع طبيب أطفال
▫️تقليل شرب الحليب البقري الى ١-٢ كاسة في اليوم.
▫️تنوع مصادر الأكل الغني بالحديد.
▫️إعطاء الطفل دواء حديد Ferrous Sulfate
▫️إعادة التحاليل بعد شهر للتأكد من الإستجابة للعلاج.
أتمنى إن هذا السرد قدم ولو القليل من الفائدة.
تابعني @matureRBC للمزيد من المواضيع المخصصة لطب الأطفال وأمراض الدم والأورام.
فضلًا رتبها @rattibha
تابعني @matureRBC للمزيد من المواضيع المخصصة لطب الأطفال وأمراض الدم والأورام.
فضلًا رتبها @rattibha
جاري تحميل الاقتراحات...